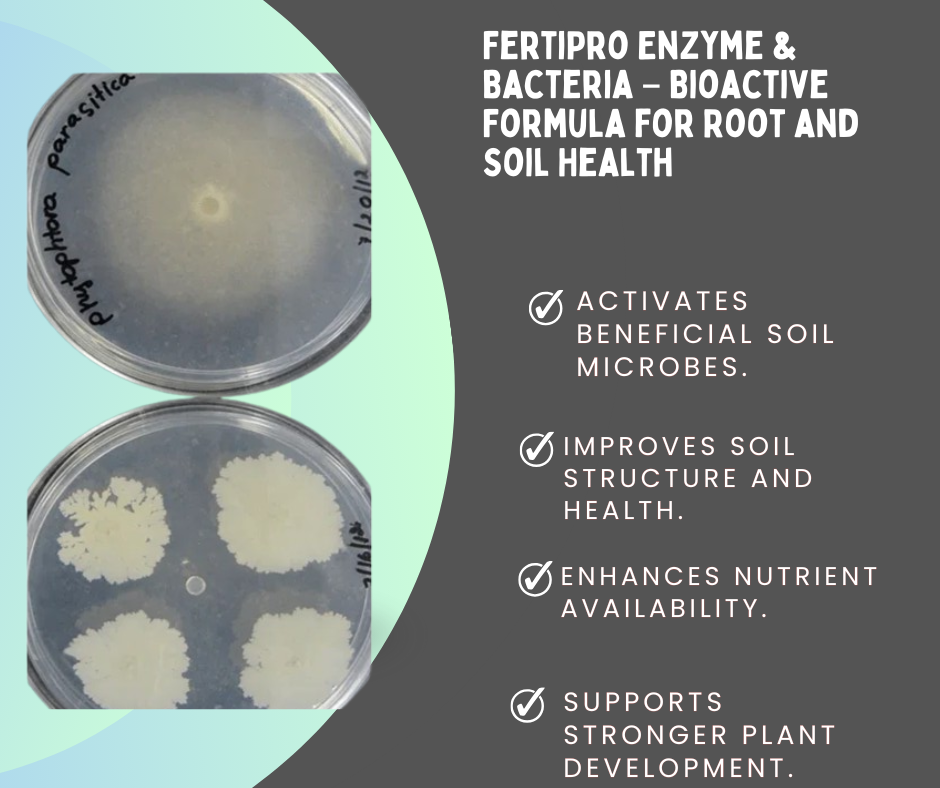
FertiPro enzyme and bacteria formula showing antifungal activity in petri dishes for improved root and soil health

FertiPro RootGuard™ | Phytophthora Root Rot Control
FertiPro RootGuard™ | Phytophthora Root Rot Control is backordered and will ship as soon as it is back in stock.
Couldn't load pickup availability
- ✅ Bioactive microbial supplement to support plant growth
- 🌿 Enhances soil microflora to improve nutrient uptake and root development
- ⚙️ Designed for sustainable horticulture, agriculture, and organic cultivation
- 🧪 Ideal for gardens, farms, and greenhouse operations seeking healthier, more robust plants.
Description
Description
FertiPro RootGuard™ – Advanced Bioactive Protection Against Phytophthora Root Rot for Fruit Trees
Revolutionizing Root Zone Protection for Mature Fruit Trees
Fruit tree growers understand that once trees reach five years and older, the investment in time, labor, and capital becomes substantial. At this stage, root health is not optional — it is the foundation of yield stability, fruit quality, and long-term orchard profitability. One of the most destructive threats to established orchards is Phytophthora root rot, a soil-borne disease capable of silently devastating root systems before symptoms are visible above ground.
We developed FertiPro RootGuard™ specifically to protect mature fruit trees from the spread of Phytophthora while restoring biological balance in the root zone. This advanced enzyme and beneficial bacteria bioactive soil booster creates a fortified rhizosphere environment that suppresses harmful pathogens and strengthens the natural defense mechanisms of fruit trees.
Understanding the Impact of Phytophthora Root Rot in Orchards
Phytophthora is a highly aggressive water mold pathogen that thrives in poorly drained or overly moist soils. For fruit tree growers managing citrus, avocado, apple, pear, mango, and stone fruit orchards, this pathogen can cause:
-
Root decay and feeder root destruction
-
Reduced nutrient and water uptake
-
Canopy thinning and leaf yellowing
-
Reduced fruit set and premature fruit drop
-
Tree decline and eventual death
The danger increases significantly in trees over five years old because their root systems are extensive and critical to maintaining full production. Once infection begins, it spreads through saturated soils, moving from tree to tree if left unmanaged.
FertiPro RootGuard™ is engineered to slow and prevent that progression directly at the root zone level.
What Makes FertiPro RootGuard™ Different
Bioactive Enzyme & Beneficial Bacteria Formula
Unlike traditional chemical fungicides that offer temporary suppression, FertiPro RootGuard™ works biologically. Our formula combines:
-
Targeted soil enzymes that break down pathogen-friendly organic residues
-
Beneficial bacteria strains that colonize the root zone
-
Rhizosphere-enhancing compounds that promote microbial diversity
This synergy creates a soil environment where Phytophthora struggles to survive and spread while supporting strong, regenerative root systems.
FertiPro RootGuard™ vs. Other Soil Treatments – Clear Performance Comparison
Choosing the right solution for Phytophthora root rot in fruit trees 5 years and older requires more than a general soil amendment. The table below highlights how FertiPro RootGuard™ outperforms conventional options.
| Feature / Benefit | FertiPro RootGuard™ | Generic Enzyme Soil Boosters | Chemical Fungicides |
|---|---|---|---|
| Specifically Targets Phytophthora Root Rot | Yes – Designed for fruit tree root protection | No – General soil improvement only | Temporary suppression only |
| Prevents Disease Spread in Root Zone | Yes – Biological competitive exclusion | Limited | No long-term prevention |
| Suitable for Trees 5+ Years Old | Yes – Engineered for mature orchards | Not specifically formulated | Yes, but may stress roots |
| Protects Entire Drip Line Area | Yes – Root perimeter coverage | Not guaranteed | Partial protection |
| Improves Soil Microbial Balance | Yes – Adds beneficial bacteria | Minimal microbial support | Often disrupts soil microbes |
| Promotes New Feeder Root Growth | Yes – Stimulates regeneration | Limited | No |
| Long-Term Soil Health Benefits | Yes – Sustainable orchard solution | Moderate | No |
| Compatible with Fertigation Systems | Yes | Sometimes | Sometimes |
| Risk of Soil Microbial Damage | None – Enhances biodiversity | Low | High |
| Supports Sustainable Agriculture Practices | Yes – Bioactive and regenerative | Limited | No |
Why Prevention Is the Most Powerful Strategy
The most effective way to manage Phytophthora root rot is through early intervention and prevention. Once a tree shows severe canopy decline and extensive root destruction, recovery becomes significantly more difficult.
FertiPro RootGuard™ performs best as a preventive protection tool. When applied before heavy disease pressure or at the earliest signs of stress, it establishes beneficial microbial dominance in the root zone, dramatically reducing the risk of pathogen spread.
Early use can:
-
Shield healthy roots from infection
-
Slow disease progression
-
Stabilize vulnerable trees
-
Preserve orchard productivity
When treatment begins early enough, many trees can be stabilized and regain vigor. However, if trees are already severely weakened and the root system is extensively damaged, some may still decline despite intervention. Biological protection strengthens natural defenses, but extremely compromised root systems may not fully recover.
This is why preventive application is strongly recommended, especially in orchards with a known history of drainage challenges or previous Phytophthora outbreaks.
Root Zone Protection for Trees 5 Years and Older
Mature fruit trees have established feeder roots and woody structural roots that demand consistent oxygen, microbial balance, and drainage efficiency. When Phytophthora attacks, the pathogen destroys feeder roots first, weakening nutrient uptake.
We designed FertiPro RootGuard™ to:
-
Protect the entire root zone perimeter
-
Enhance microbial competition against pathogens
-
Stimulate root regeneration
-
Improve soil structure and aeration
-
Strengthen tree resilience during wet seasons
By applying directly to the soil around the drip line, growers reinforce the biological shield where it matters most.
How FertiPro RootGuard™ Prevents Disease Spread
1. Competitive Microbial Colonization
Beneficial bacteria establish dominance in the root zone, reducing space and resources available for Phytophthora.
2. Enzymatic Breakdown of Pathogen Support Material
Specific enzymes degrade organic matter that would otherwise support pathogen proliferation.
3. Improved Soil Drainage and Structure
Balanced microbial life enhances soil aggregation, improving aeration and minimizing water stagnation — a key factor in Phytophthora outbreaks.
4. Strengthened Root Immunity
Healthier roots produce stronger natural defense responses, limiting infection severity.
Restoring Orchard Productivity After Early-Stage Root Rot
Trees affected in early stages often show gradual decline rather than immediate collapse. Intervention with FertiPro RootGuard™ can:
-
Promote new feeder root growth
-
Improve nutrient absorption efficiency
-
Restore canopy density
-
Increase fruit size and uniformity
-
Extend orchard lifespan
The earlier treatment begins, the greater the chance of recovery. Severely weakened trees with advanced root destruction may not respond fully, which reinforces the importance of proactive orchard management.
Enhancing Soil Health Beyond Disease Control
Healthy soil is the cornerstone of sustainable fruit production. Beyond disease suppression, FertiPro RootGuard™ contributes to:
-
Enhanced microbial biodiversity
-
Improved organic matter decomposition
-
Better water infiltration
-
Increased nutrient mineralization
-
Balanced pH stability
These improvements compound over time, creating a resilient orchard ecosystem capable of resisting future pathogen pressure.
Conclusion: Long-Term Root Protection Starts Before the Crisis
Phytophthora root rot remains one of the most damaging threats to established fruit trees. Waiting for visible symptoms often means the disease has already progressed deep into the root system.
FertiPro RootGuard™ delivers advanced bioactive root zone protection and is most powerful when used preventively. By strengthening microbial balance before severe infection occurs, growers dramatically improve tree survival rates and orchard stability.
Early action protects investment. Delayed action limits recovery potential.
For fruit trees five years and older, safeguarding the root zone is not optional — it is essential for sustained productivity and long-term orchard success.
Payment & Security
Payment methods
Your payment information is processed securely. We do not store credit card details nor have access to your credit card information.